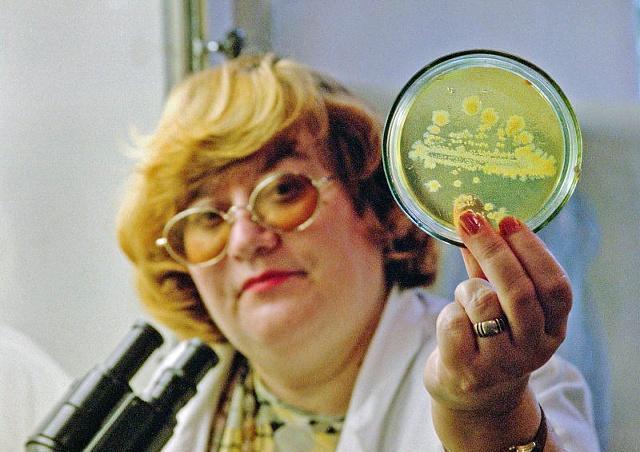
睡眠|世卫组织拉入“黑名单”的常见菜,其中一种可能是你的最爱

文章图片

文章图片
生活中为了身体的健康 , 我们常常劝告他人多吃水果和蔬菜 , 水果蔬菜是生活中最常接触到的事物 , 因为水果蔬菜含有大量的营养物质 , 可以更好的补充身体所需要的物质 , 而且有利于加快身体的新陈代谢 , 帮助身体更加健康 , 但是任何事物都有两面性的 , 并不是说所有的食物都可以放肆去吃 , 有些蔬菜是不能随便吃的 , 否则会给身体造成负面作用 , 有的蔬菜含有有毒物质 , 进入人体将会产生细胞病变 , 长期使用会给身体带来伤害 , 今天小编就给大家介绍一些蔬菜 , 这些蔬菜已经被世卫组织拉入黑名单 , 看看有没有你想吃的 。
世卫组织拉入“黑名单”的常见菜 , 其中一种可能是你的最爱
西葫芦
这个季节正是大量西葫芦上市的好时节 , 西葫芦的营养价值非常丰富 , 而且价格优惠 , 西葫芦的食用方法是非常多的 , 任何做法都非常美味 。 虽然西葫芦对人体有益 , 但是西葫芦并不适合在高温下进行储藏 。 因为容易出现丙烯酰胺 , 丙烯酰胺是一种致癌物质 , 长期食用会给身体带来严重的伤害 , 所以在进行烹饪西葫芦的时候最好要注意火候 , 避免产生对人体有害的物质 。
娃娃菜
娃娃菜是人们都非常喜欢吃的蔬菜 , 尤其是在吃火锅的时候都会点一盘娃娃菜 , 因为娃娃菜比较的爽口 。 在超市里我们见到的娃娃菜包装干净 , 比较有食欲 , 但是有一些不良商家为了提高娃娃菜的储存力 , 在包装娃娃菜的时候会加入甲醛溶液 , 甲醛能更好的保鲜食品 , 但是却含有致癌物质 , 长期吃容易诱发体内甲醛超标 , 引起白血病 , 所以在购买娃娃菜的时候就应该多加留心 , 避免买到对人体有害的娃娃菜 。
蕨菜
【睡眠|世卫组织拉入“黑名单”的常见菜,其中一种可能是你的最爱】蕨菜生长环境较复杂 , 大多生长在山里 , 蕨菜也被认为一种大自然的野菜 , 虽然没有受到农药的喷洒 , 不含残留农药 , 但是蕨菜本身却含有致癌物质 , 原蕨苷进入人体容易导致肠胃病变 , 虽然蕨菜在烹饪的时候味道比较鲜美 , 而且凉拌着吃比较清爽 , 但是为了身体的健康也应该尽量少吃蕨菜 , 避免给身体带来伤害 。
以上这些蔬菜是日常生活中经常食用的 , 它们虽然营养丰富 , 但是却存在有害物质 , 在平时尽量少吃 , 今天小编向大家分享的健康知识就到这里 , 希望大家能够转告给家人 , 你还知道哪些常见菜会存在对身体不利的物质呢?可以在下方评论区留言 , 我们一起进行探讨 , 感谢您的阅读和推荐 。
- 治疗睡眠有妙招,红会医院睡眠医学中心黑科技亮相健博会
- 晚上吃这几种水果,不仅祛除体内湿气,还能够提高睡眠质量
- 长期失眠的人想睡得更安稳,这几种食物可以改善睡眠
- 难以入睡眠的原因可分为以下几个原因,对照看看吧
- 睡眠|血管堵塞的罪魁祸首公布了,并非大鱼大肉,望你早做了解,尽早避免
- 睡眠也讲究质量,什么时间点最好?了解下
- 我省各地组织开展全国老年健康宣传周系列活动
- 睡眠|牙齿变灰色是怎么回事?
- 睡眠|你几点睡,就是什么命!(很准)
- 熬夜|这三类常见的蔬菜,早就被世界卫生组织拉黑,可能是你餐桌的常客
